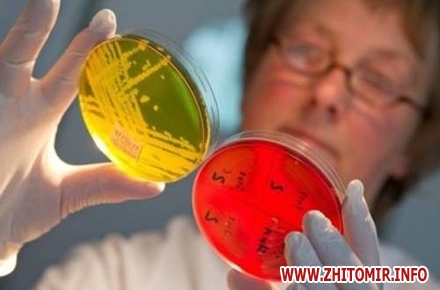

Останні роки в Житомирській області як і в цілому по Україні відмічається підвищений рівень захворюваності на ротавірусну інфекцію.
Про це інформує прес-служба ДУ «Житомирський обласний лабораторний центр міністерства охорони здоров’я України».
«Так за 2015 рік зареєстровано 311 випадків по області, показник на 100 тисяч населення становить 24,3, в 2016 році – 158 випадків захворювання, показник 12,3 (показник захворюваності по Україні становить 28,8 та 28,3)», - йдеться у повідомленні.
За інформацією спеціалістів, за 9 місяців поточного року кількість захворілих зростає: зареєстровано вже 189 випадків, показник 14,74 що на 62% вище за аналогічний період минулого року.
«Найбільш вразливою категорією є вікова група дітей до року та 1-9 років. У зв’язку з використанням сучасних лабораторних методів досліджень при постановці діагнозу найвищі рівні захворюваності відмічаються в місті Житомирі та Бердичівському районі. Поодинокі випадки були в Житомирському, Олевському та Черняхівському районах. Фахівцями обласного лабораторного центру проводяться протиепідемічні заходи у вогнищах гострих кишкових інфекцій. Вірусологічна лабораторія на рота вірусну інфекцію з діагностичною метою досліджує клінічний матеріал від хворих та контактних осіб, а також досліджує матеріал зовнішнього середовища (питна вода, стічна вода, вода відкритих водоймищ, вода басейнів, що використовують водопровідну воду, продукти харчування, в тому числі дитячого, змиви з предметів вжитку, грунт) на наявність збудника інфекції», - поінформували у лабораторному центрі.
Нагадаємо, 12 вересня у Житомирській області 6 працівників, які харчувалися в їдальні комбінату, госпіталізували з кишковою інфекцією.
Як повідомляв Житомир.info, за 6 місяців 2017 року в Житомирській області зареєстровано 2 спалахи інфекцій кишкової групи, внаслідок яких постраждало 32 дитини віком до 17 років. За аналогічний період минулого року було зареєстровано 6 спалахів, де перехворіло 43 особи, в т.ч. 19 дітей до 17 років.
























